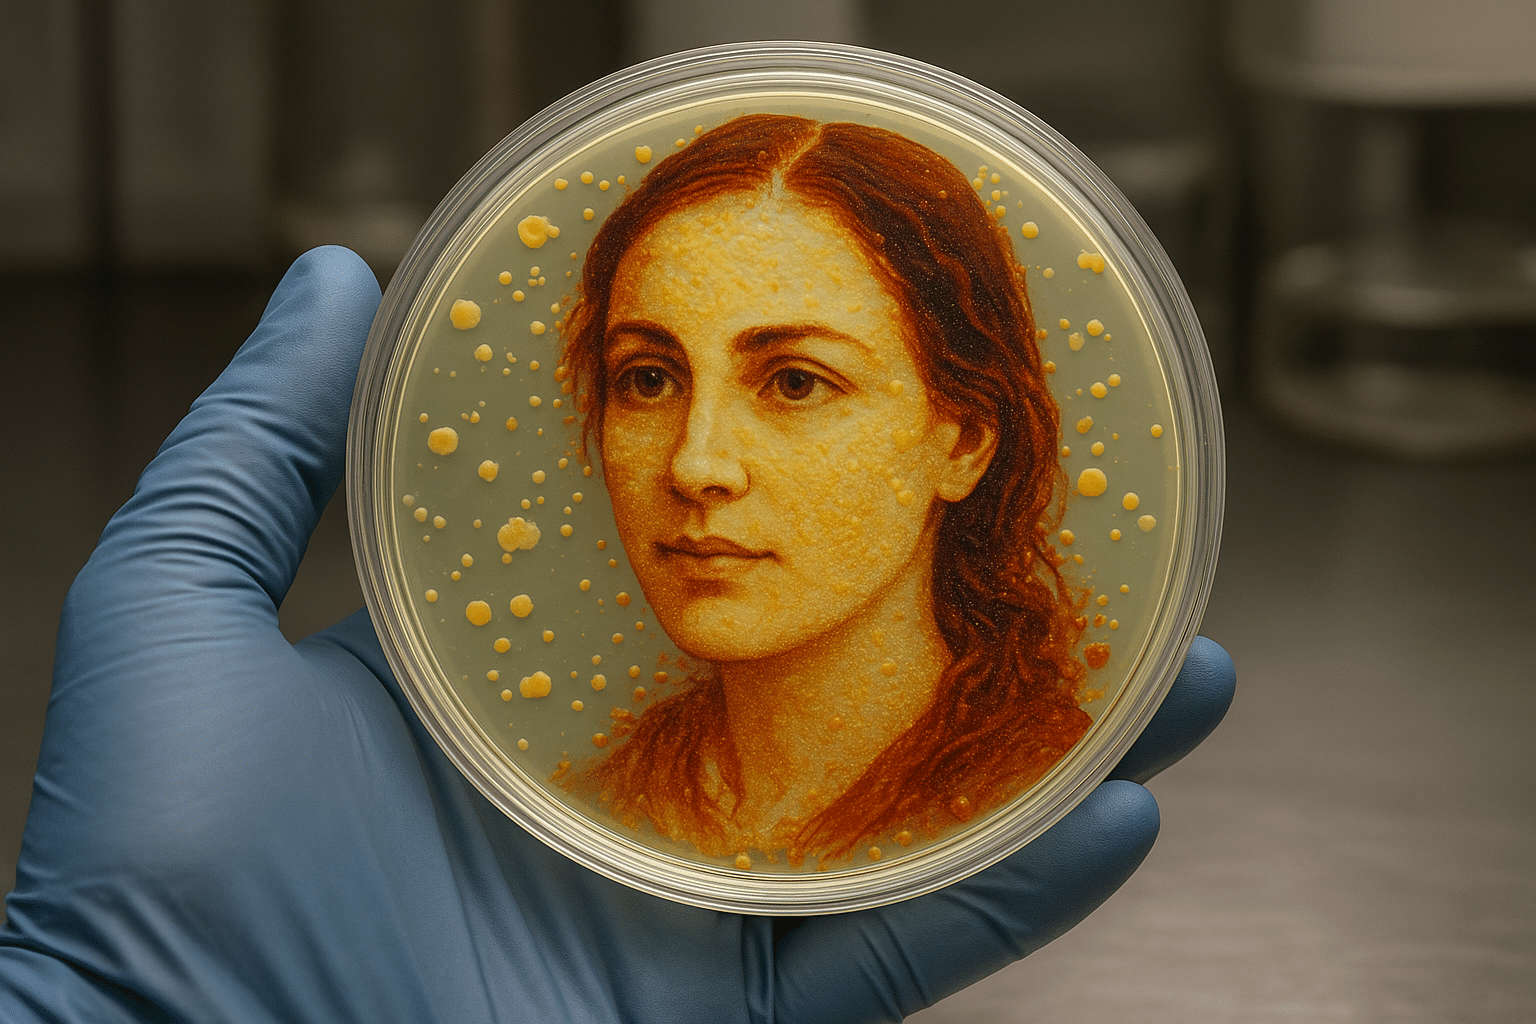
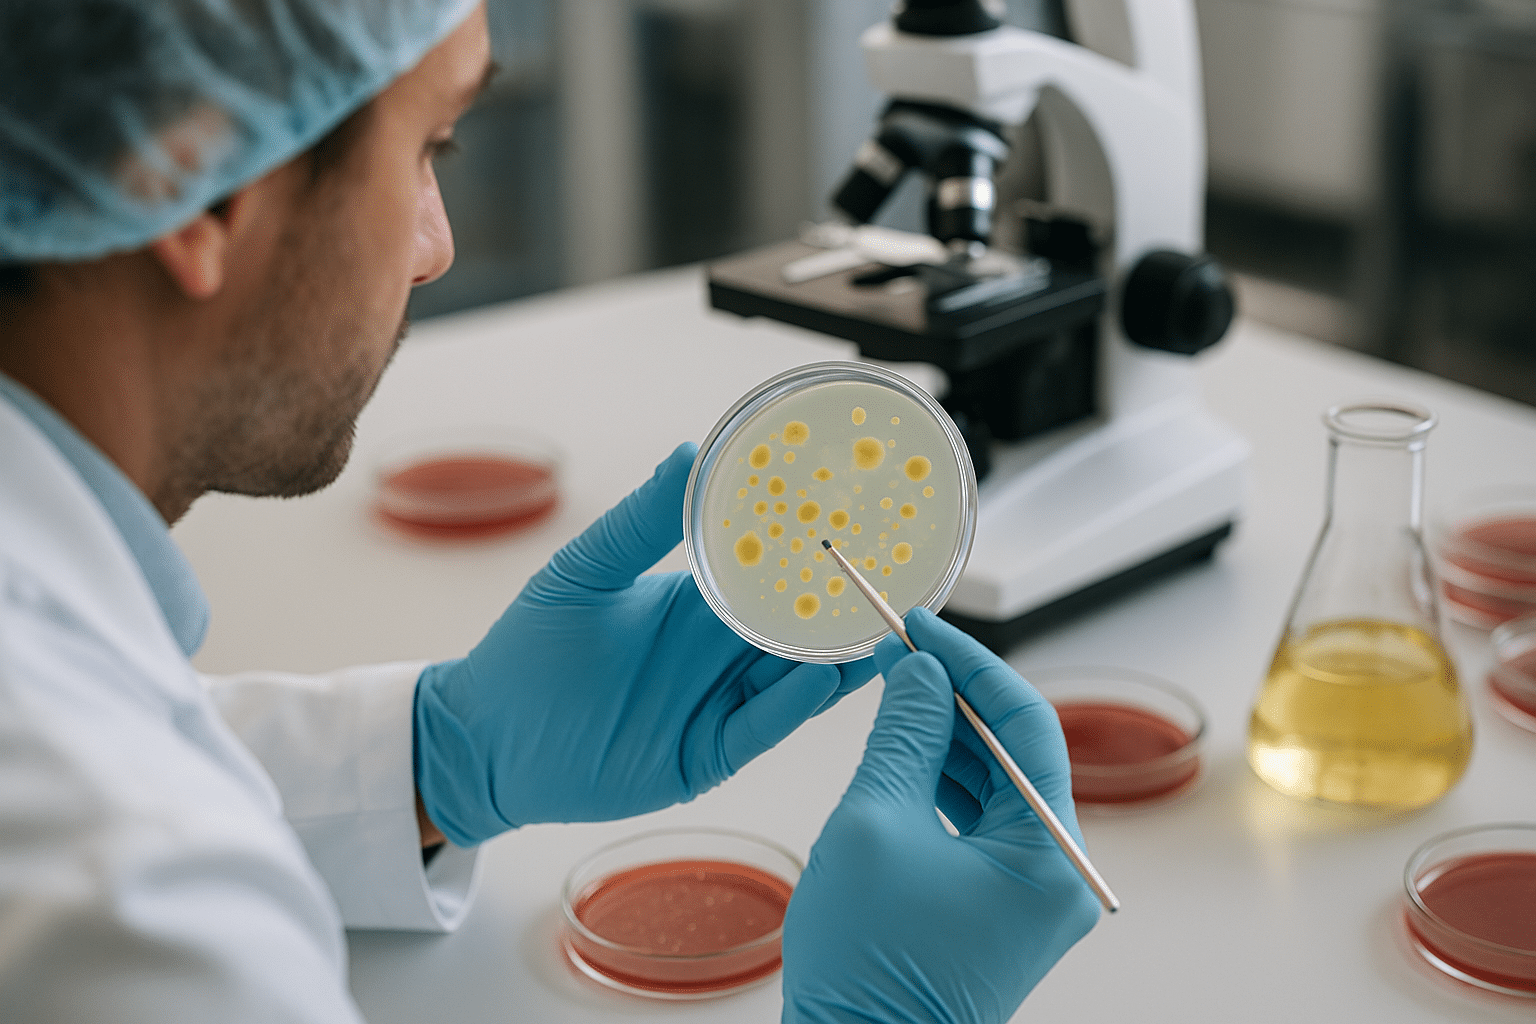

5G Activation Guide for Your Mobile Device
# HTML Article: 5G Liberar no Celular Unlocking 5G on your smartphone opens the door to lightning-fast internet speeds, seamless streaming, and a significantly enhanced mobile experience that transforms how you connect daily. The rollout of 5G technology represents one of the most significant advancements in mobile connectivity in recent years. However, many smartphone users … Ler mais